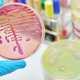
Nepričakovani zaveznik v boju proti superbakterijam

Znanstveniki so razvili povsem nov antibiotik, ki bi lahko premagal Acinetobacter baumannii, eno od treh superbakterij, za katere velja, da predstavljajo največjo grožnjo zdravju zaradi njihove široke odpornosti proti zdravilom. … · Siol.net · 1L
superbakterija antibiotiki zdravljenje poskusi bolnik zdravila objavi tvitaj

Znanstvene raziskave o najpomembnejši žlezi našega telesa so nejasne in ne podajajo jasnih odgovorov o vzrokih nepravilnega delovanja. Ščitnica namreč… Po zaslugi Anthonyja Williama, avtorja svetovne uspešnice Medicinski medij: Zdravljenje … · Sensa · 4L
Zdravilo proti artritisu utrjuje našo zadnjo črto obrambe pred superbakterijami, so ugotovili raziskovalci Univerze v Hongkongu, ki so pokazali, kako lahko onesposobimo bakterije, ki so razvile odpornost pred antibiotiki. V … · Siol.net · 5L
znanost superbakterija bakterija antibiotiki odpornost raziskava objavi tvitaj